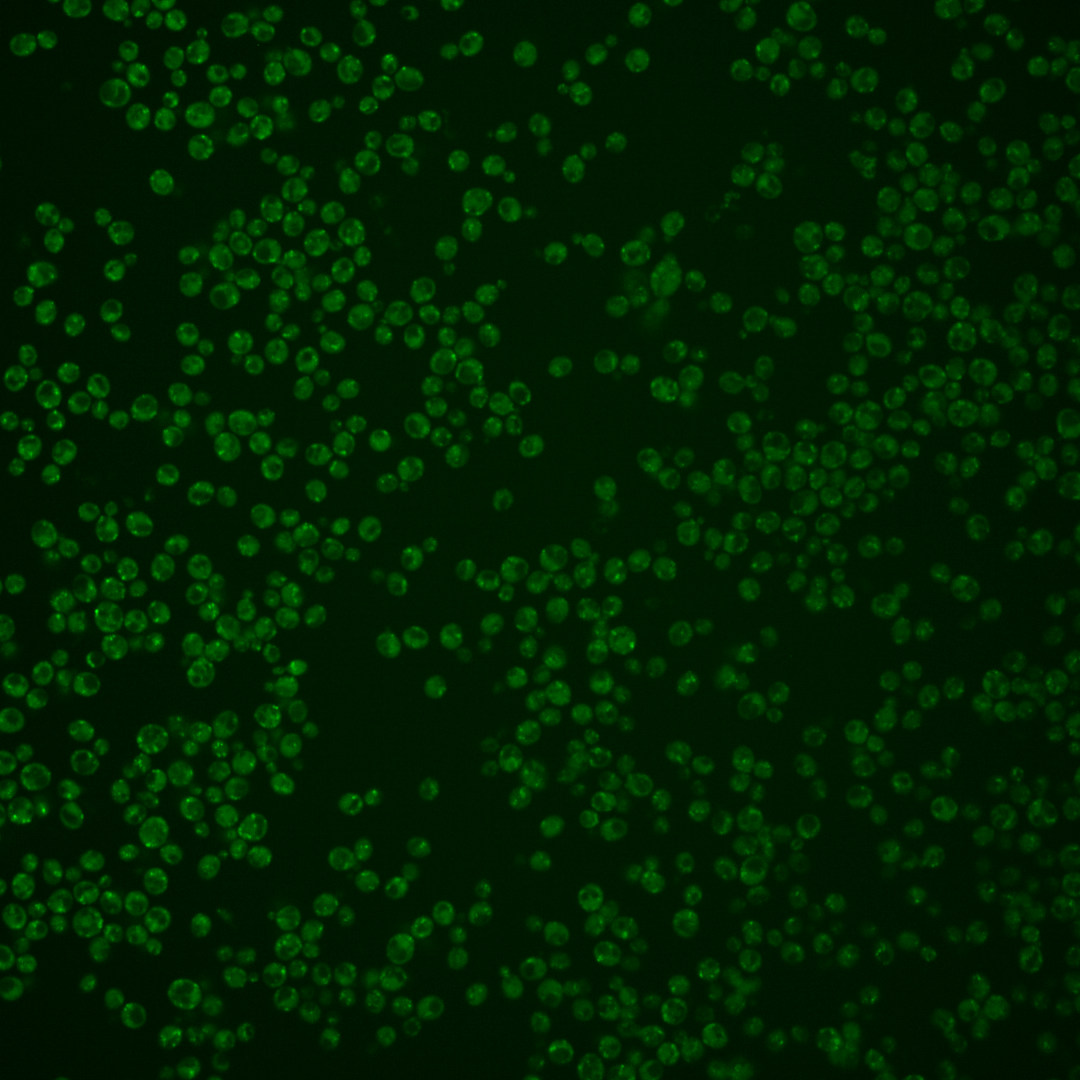
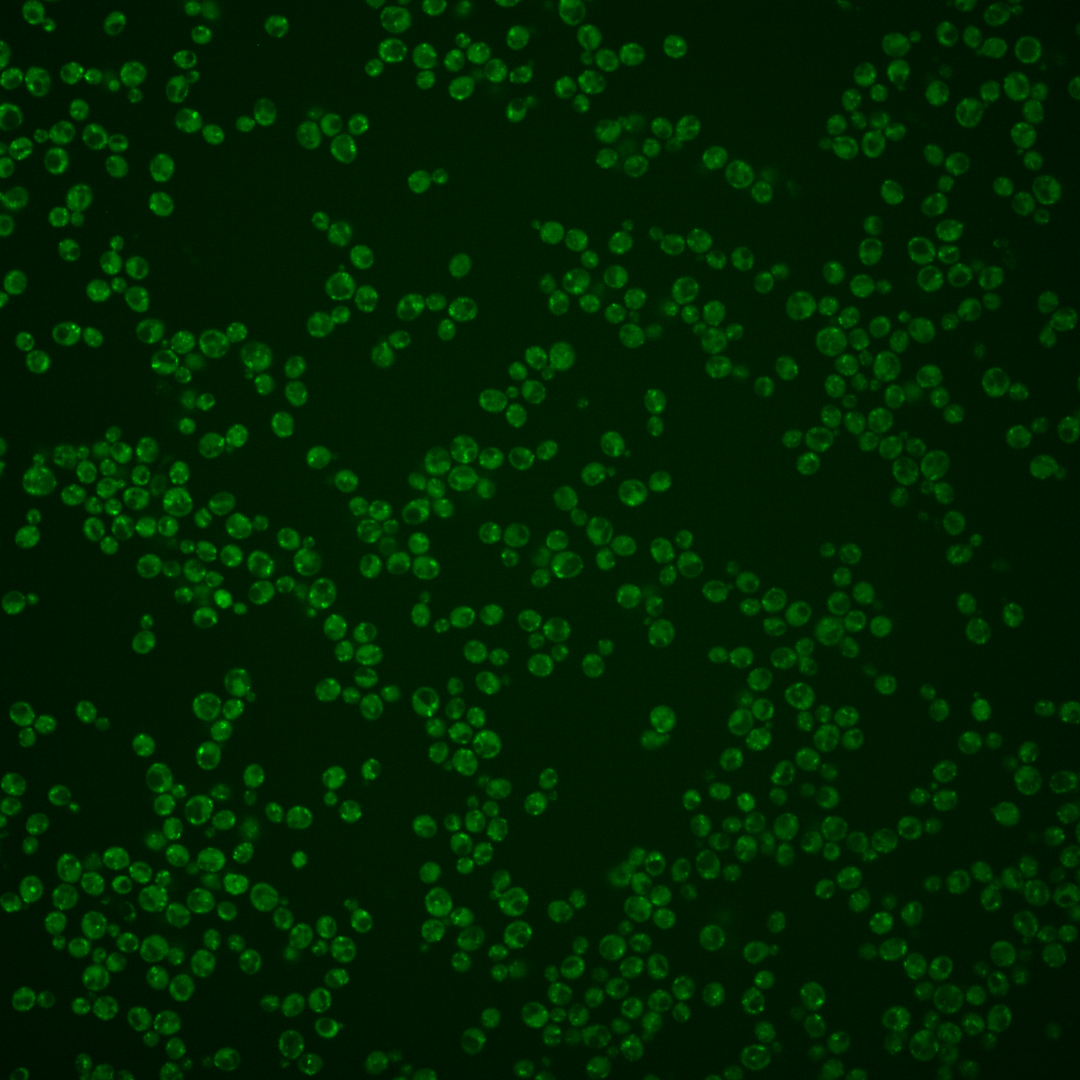
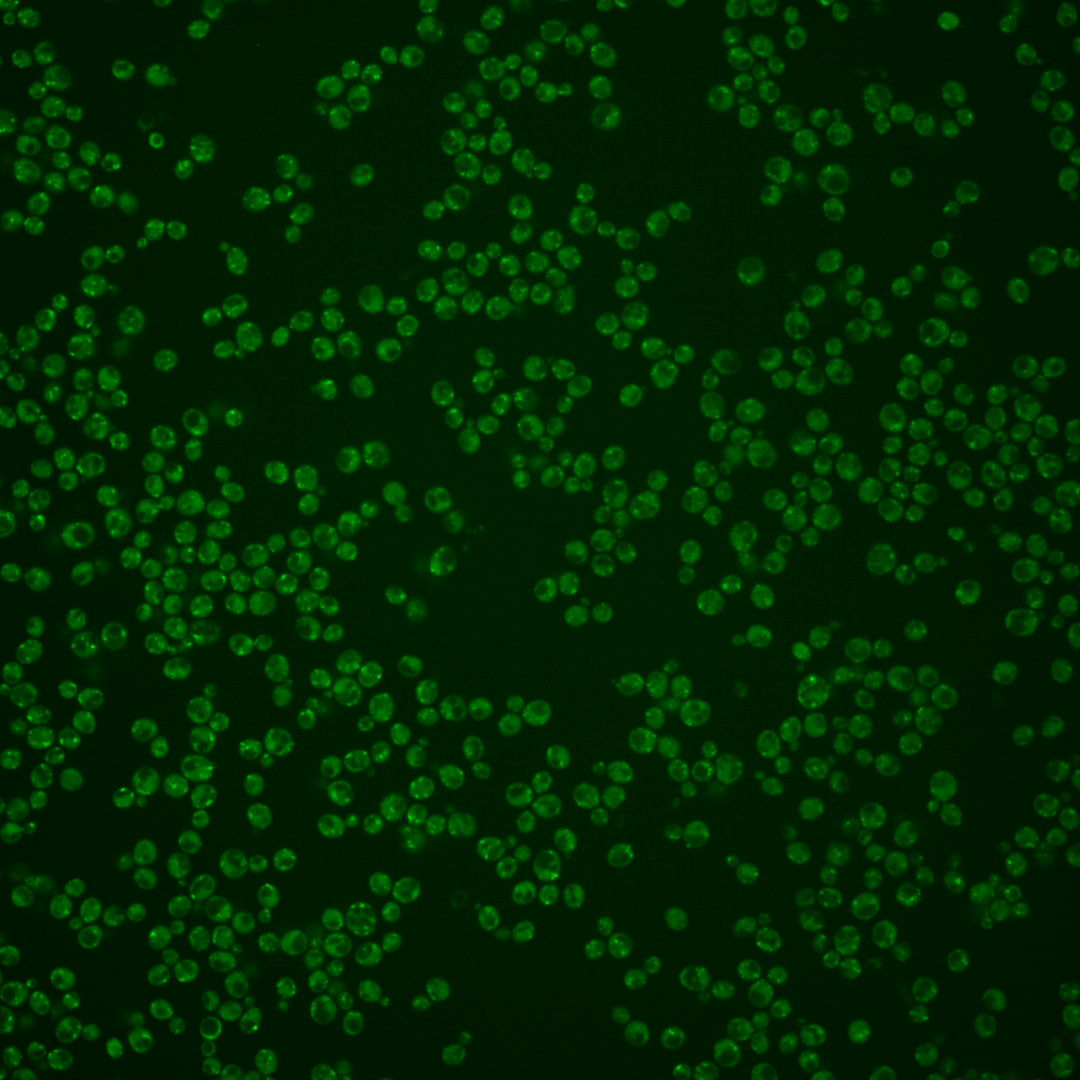
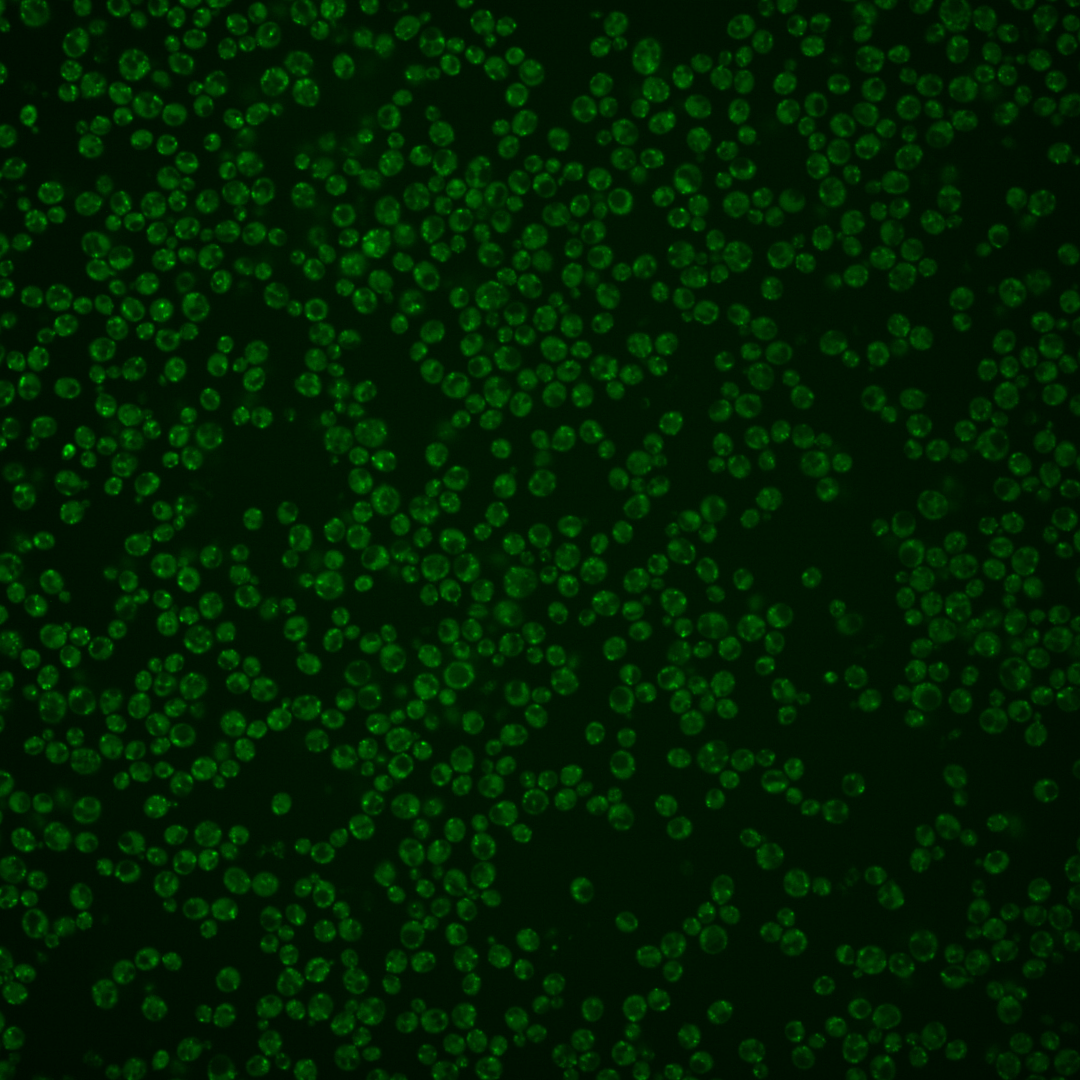
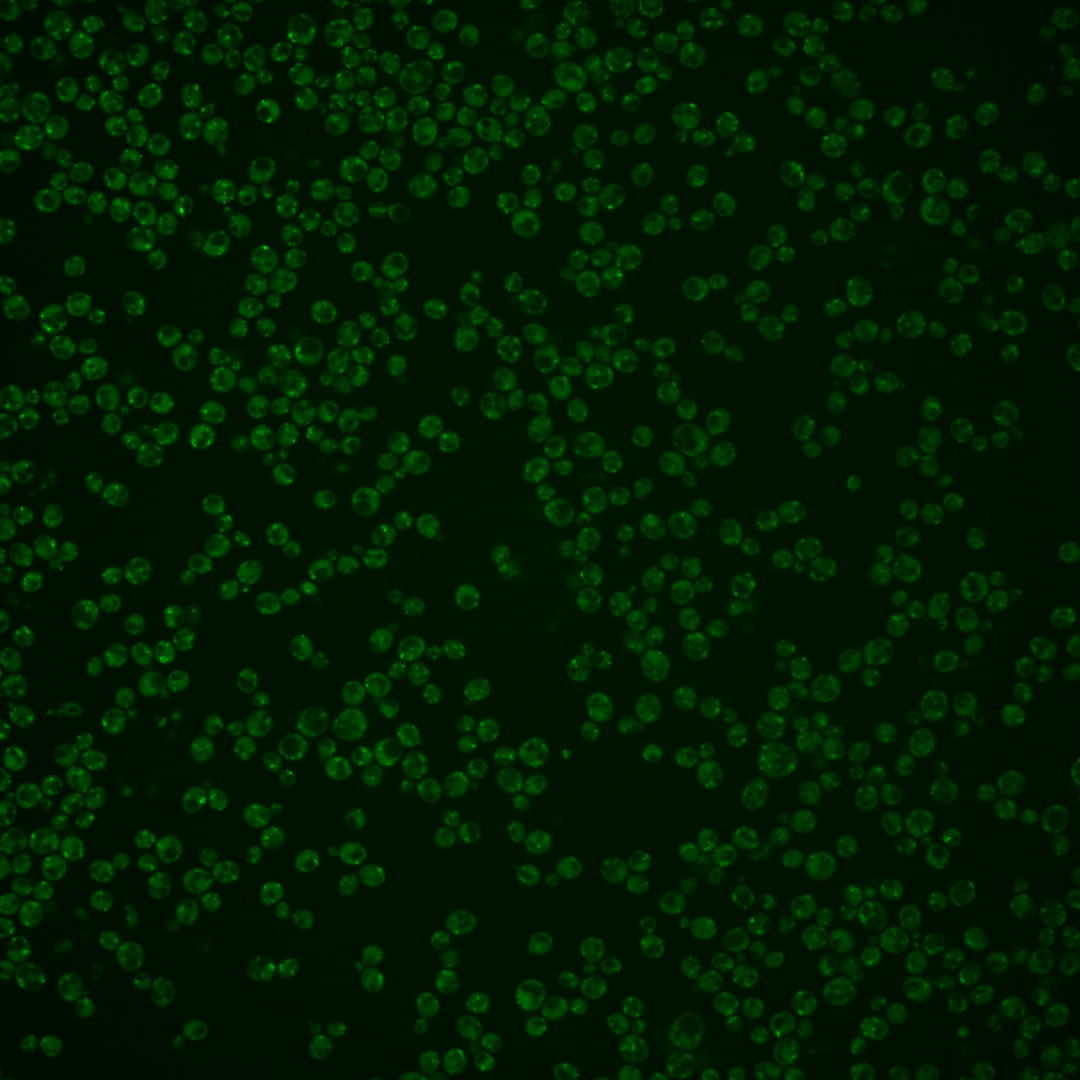

| Standard name | |
|---|---|
| Human Ortholog | |
| Description | Mu3-like subunit of the clathrin associated protein complex (AP-3); functions in transport of alkaline phosphatase to the vacuole via the alternate pathway |
Micrographs




















































































Sub-cellular Localization
Yeast GFP Assignment
Protein Abundance
Localization Change
External localization resources
| ensLOC | DeepLoc | |||||||||||||||||||||||
|---|---|---|---|---|---|---|---|---|---|---|---|---|---|---|---|---|---|---|---|---|---|---|---|---|
| Localization | WT1 | WT2 | WT3 | RAP60 | RAP140 | RAP220 | RAP300 | RAP380 | RAP460 | RAP540 | RAP620 | RAP700 | HU80 | HU120 | HU160 | rpd3Δ_1 | rpd3Δ_2 | rpd3Δ_3 | WT1 | WT2 | WT3 | AF100 | AF140 | AF180 |
| Cortical Patches | 0 | 12 | 3 | 2 | 1 | 0 | 0 | 5 | 3 | 0 | 2 | 4 | 2 | 7 | 7 | 9 | 9 | 6 | 1 | 7 | 11 | 5 | 10 | 10 |
| Bud | 1 | 2 | 11 | 11 | 19 | 39 | 36 | 53 | 52 | 47 | 53 | 42 | 1 | 3 | 3 | 4 | 4 | 3 | 0 | 1 | 0 | 0 | 0 | 0 |
| Bud Neck | 0 | 0 | 0 | 0 | 0 | 0 | 0 | 0 | 0 | 0 | 0 | 0 | 0 | 0 | 0 | 0 | 0 | 0 | 0 | 1 | 0 | 0 | 0 | 0 |
| Bud Site | 0 | 0 | 2 | 0 | 1 | 8 | 8 | 9 | 19 | 15 | 5 | 15 | 0 | 0 | 0 | 0 | 0 | 0 | – | – | – | – | – | – |
| Cell Periphery | 0 | 1 | 1 | 1 | 1 | 3 | 4 | 0 | 3 | 3 | 0 | 0 | 0 | 0 | 1 | 2 | 1 | 1 | 0 | 0 | 0 | 0 | 0 | 0 |
| Cytoplasm | 0 | 21 | 15 | 9 | 25 | 23 | 17 | 21 | 19 | 14 | 23 | 13 | 3 | 10 | 13 | 8 | 7 | 11 | 0 | 1 | 0 | 0 | 0 | 1 |
| Endoplasmic Reticulum | 2 | 17 | 0 | 2 | 1 | 3 | 5 | 6 | 3 | 2 | 5 | 4 | 4 | 5 | 3 | 4 | 4 | 4 | 0 | 2 | 1 | 0 | 3 | 1 |
| Endosome | 0 | 2 | 12 | 6 | 64 | 31 | 17 | 39 | 8 | 14 | 8 | 20 | 4 | 23 | 47 | 35 | 16 | 23 | 21 | 58 | 38 | 22 | 56 | 48 |
| Golgi | 2 | 13 | 8 | 15 | 9 | 0 | 1 | 2 | 0 | 1 | 0 | 0 | 18 | 53 | 42 | 48 | 61 | 47 | 45 | 86 | 100 | 38 | 182 | 179 |
| Mitochondria | 46 | 245 | 168 | 185 | 251 | 543 | 509 | 530 | 444 | 488 | 419 | 423 | 52 | 75 | 41 | 18 | 11 | 10 | 15 | 101 | 27 | 18 | 55 | 45 |
| Nucleus | 0 | 3 | 1 | 0 | 2 | 1 | 4 | 5 | 1 | 2 | 4 | 1 | 0 | 1 | 2 | 0 | 1 | 0 | 0 | 1 | 0 | 0 | 0 | 0 |
| Nuclear Periphery | 0 | 1 | 0 | 0 | 0 | 1 | 3 | 2 | 1 | 2 | 4 | 2 | 0 | 0 | 1 | 1 | 2 | 0 | 0 | 0 | 0 | 0 | 1 | 0 |
| Nucleolus | 2 | 0 | 2 | 2 | 1 | 10 | 18 | 28 | 15 | 17 | 21 | 9 | 0 | 1 | 0 | 0 | 0 | 0 | 0 | 0 | 0 | 0 | 0 | 0 |
| Peroxisomes | 0 | 1 | 4 | 4 | 21 | 31 | 22 | 47 | 29 | 47 | 29 | 43 | 2 | 3 | 23 | 4 | 2 | 3 | 2 | 12 | 20 | 11 | 35 | 27 |
| SpindlePole | 0 | 2 | 3 | 4 | 11 | 26 | 25 | 39 | 13 | 25 | 17 | 40 | 1 | 5 | 12 | 10 | 7 | 8 | 1 | 4 | 0 | 0 | 1 | 0 |
| Vac/Vac Membrane | 4 | 7 | 4 | 7 | 18 | 14 | 5 | 6 | 4 | 5 | 6 | 5 | 4 | 11 | 12 | 10 | 10 | 12 | 1 | 26 | 1 | 2 | 3 | 3 |
| Unique Cell Count | 48 | 277 | 200 | 205 | 333 | 606 | 570 | 631 | 488 | 550 | 474 | 488 | 71 | 159 | 154 | 116 | 110 | 110 | 92 | 309 | 206 | 101 | 353 | 321 |
| Labelled Cell Count | 57 | 327 | 234 | 248 | 425 | 733 | 674 | 792 | 614 | 682 | 596 | 621 | 91 | 197 | 207 | 153 | 135 | 128 | 92 | 309 | 206 | 101 | 353 | 321 |
Yeast GFP Assignment
Protein Abundance
| Screen | WT1 | WT2 | WT3 | RAP60 | RAP140 | RAP220 | RAP300 | RAP380 | RAP460 | RAP540 | RAP620 | RAP700 | HU80 | HU120 | HU160 | rpd3Δ_1 | rpd3Δ_2 | rpd3Δ_3 | AF100 | AF140 | AF180 |
|---|---|---|---|---|---|---|---|---|---|---|---|---|---|---|---|---|---|---|---|---|---|
| Mean Cell GFP Intensity (1e-4) | 6.1 | 5.6 | 6.3 | 6.1 | 6.3 | 4.8 | 4.9 | 5.4 | 4.8 | 4.8 | 4.8 | 4.7 | 7.6 | 7.6 | 7.8 | 8.3 | 8.1 | 8.1 | 5.8 | 7.3 | 7.2 |
| Std Deviation (1e-4) | 1.1 | 0.8 | 1.7 | 1.5 | 2.0 | 1.3 | 1.5 | 1.6 | 1.3 | 1.1 | 1.6 | 1.2 | 1.2 | 1.0 | 1.2 | 1.5 | 1.4 | 1.2 | 0.7 | 1.0 | 1.1 |
| Intensity Change (Log2) | – | – | – | -0.04 | 0.0 | -0.38 | -0.37 | -0.23 | -0.39 | -0.39 | -0.39 | -0.43 | 0.27 | 0.27 | 0.31 | 0.39 | 0.37 | 0.36 | -0.11 | 0.21 | 0.2 |
Localization Change
| Localization | RAP60 | RAP140 | RAP220 | RAP300 | RAP380 | RAP460 | RAP540 | RAP620 | RAP700 | HU80 | HU120 | HU160 | rpd3Δ_1 | rpd3Δ_2 | rpd3Δ_3 |
|---|---|---|---|---|---|---|---|---|---|---|---|---|---|---|---|
| Cortical Patches | 0 | 0 | 0 | 0 | 0 | 0 | 0 | 0 | 0 | 0 | 0 | 0 | 0 | 0 | 0 |
| Bud | -0.1 | 0.1 | 0 | 0 | 1.3 | 0 | 0 | 0 | 0 | 0 | -1.8 | -1.7 | -0.8 | -0.7 | 0 |
| Bud Neck | 0 | 0 | 0 | 0 | 0 | 0 | 0 | 0 | 0 | 0 | 0 | 0 | 0 | 0 | 0 |
| Bud Site | 0 | 0 | 0 | 0 | 0 | 0 | 0 | 0 | 0 | 0 | 0 | 0 | 0 | 0 | 0 |
| Cell Periphery | 0 | 0 | 0 | 0 | 0 | 0 | 0 | 0 | 0 | 0 | 0 | 0 | 0 | 0 | 0 |
| Cytoplasm | -1.3 | 0 | -2.1 | -2.8 | -2.5 | -2.0 | -3.1 | -1.4 | -2.9 | 0 | -0.4 | 0.3 | -0.2 | -0.4 | 0.8 |
| Endoplasmic Reticulum | 0 | 0 | 0 | 0 | 0 | 0 | 0 | 0 | 0 | 0 | 0 | 0 | 0 | 0 | 0 |
| Endosome | -1.5 | 4.2 | 0 | 0 | 0.1 | 0 | 0 | 0 | 0 | 0 | 2.7 | 6.1 | 5.8 | 2.5 | 4.0 |
| Golgi | 1.4 | -0.8 | 0 | 0 | 0 | 0 | 0 | 0 | 0 | 5.2 | 7.4 | 6.2 | 8.4 | 10.4 | 8.5 |
| Mitochondria | 1.9 | -2.4 | 0 | 0 | 0 | 0 | 0 | 0 | 0 | -2.0 | -7.4 | -10.9 | -11.9 | -12.6 | -12.8 |
| Nucleus | 0 | 0 | 0 | 0 | 0 | 0 | 0 | 0 | 0 | 0 | 0 | 0 | 0 | 0 | 0 |
| Nuclear Periphery | 0 | 0 | 0 | 0 | 0 | 0 | 0 | 0 | 0 | 0 | 0 | 0 | 0 | 0 | 0 |
| Nucleolus | 0 | 0 | 0 | 0 | 2.3 | 0 | 0 | 0 | 0 | 0 | 0 | 0 | 0 | 0 | 0 |
| Peroxisomes | 0 | 2.3 | 0 | 0 | 2.8 | 0 | 0 | 0 | 0 | 0 | 0 | 4.5 | 0 | 0 | 0 |
| SpindlePole | 0 | 1.3 | 0 | 0 | 2.6 | 0 | 0 | 0 | 0 | 0 | 0 | 2.9 | 0 | 0 | 0 |
| Vacuole | 0.9 | 1.9 | 0 | 0 | 0 | 0 | 0 | 0 | 0 | 0 | 2.3 | 2.6 | 2.8 | 0 | 3.4 |
External localization resources
Images






























Protein Concentration and Protein Localization Data
| R1 | R2 | R3 | ||||||||||||||||
|---|---|---|---|---|---|---|---|---|---|---|---|---|---|---|---|---|---|---|
| G1 Pre-START | G1 Post-START | S/G2 | Metaphase | Anaphase | Telophase | G1 Pre-START | G1 Post-START | S/G2 | Metaphase | Anaphase | Telophase | G1 Pre-START | G1 Post-START | S/G2 | Metaphase | Anaphase | Telophase | |
| Concentration | 2.8841 | 3.2139 | 3.0016 | 2.4904 | 2.5232 | 2.8991 | 4.3235 | 5.2519 | 4.772 | 4.2779 | 4.2306 | 4.844 | 3.3282 | 3.9251 | 3.5402 | 3.7322 | 3.4615 | 3.612 |
| Actin | 0.0324 | 0.0095 | 0.0233 | 0.0011 | 0.0027 | 0.0223 | 0.0427 | 0.0251 | 0.0132 | 0.0025 | 0.0038 | 0.0163 | 0.0298 | 0.0324 | 0.0338 | 0.0048 | 0.1317 | 0.022 |
| Bud | 0.0012 | 0.0002 | 0.0004 | 0.0002 | 0 | 0.0001 | 0.0004 | 0.0005 | 0.0003 | 0.0001 | 0.0002 | 0.0001 | 0.0004 | 0.0004 | 0.0004 | 0.0001 | 0.0014 | 0.0001 |
| Bud Neck | 0.0006 | 0.0004 | 0.0004 | 0.0002 | 0.0002 | 0.0004 | 0.0005 | 0.0005 | 0.0006 | 0.0002 | 0.0003 | 0.0006 | 0.0008 | 0.0004 | 0.0004 | 0.0002 | 0.0003 | 0.0005 |
| Bud Periphery | 0.0004 | 0.0001 | 0.0006 | 0.0002 | 0 | 0.0001 | 0.0003 | 0.0003 | 0.0002 | 0.0001 | 0.0002 | 0.0001 | 0.0003 | 0.0002 | 0.0002 | 0.0001 | 0.0016 | 0.0001 |
| Bud Site | 0.0021 | 0.0011 | 0.0013 | 0.0004 | 0.0001 | 0.0002 | 0.0015 | 0.0078 | 0.0028 | 0.0001 | 0.0003 | 0.0002 | 0.0015 | 0.0019 | 0.0017 | 0.0001 | 0.0016 | 0.0002 |
| Cell Periphery | 0.0001 | 0 | 0.0001 | 0 | 0 | 0 | 0.0001 | 0.0001 | 0.0001 | 0 | 0.0001 | 0 | 0.0001 | 0.0001 | 0.0001 | 0 | 0 | 0 |
| Cytoplasm | 0.0036 | 0.0054 | 0.0035 | 0.0019 | 0.0017 | 0.0033 | 0.0055 | 0.0169 | 0.0036 | 0.0017 | 0.0021 | 0.0018 | 0.0029 | 0.0334 | 0.0037 | 0.001 | 0.0012 | 0.002 |
| Cytoplasmic Foci | 0.1315 | 0.1215 | 0.1074 | 0.1215 | 0.1281 | 0.0752 | 0.1173 | 0.1668 | 0.1281 | 0.1089 | 0.1074 | 0.1036 | 0.1617 | 0.1208 | 0.1159 | 0.0779 | 0.0732 | 0.0895 |
| Eisosomes | 0.0001 | 0 | 0.0001 | 0 | 0 | 0 | 0.0001 | 0.0001 | 0.0001 | 0 | 0 | 0 | 0.0001 | 0 | 0 | 0 | 0.0001 | 0 |
| Endoplasmic Reticulum | 0.0006 | 0.0005 | 0.0006 | 0.0004 | 0.0003 | 0.0006 | 0.0023 | 0.0007 | 0.0006 | 0.0004 | 0.0006 | 0.0005 | 0.0006 | 0.0008 | 0.0011 | 0.0004 | 0.0004 | 0.0009 |
| Endosome | 0.2355 | 0.2565 | 0.2821 | 0.3204 | 0.2251 | 0.2017 | 0.3185 | 0.244 | 0.2987 | 0.2538 | 0.3054 | 0.2107 | 0.2302 | 0.1736 | 0.2934 | 0.2608 | 0.267 | 0.2197 |
| Golgi | 0.4952 | 0.5588 | 0.5349 | 0.5285 | 0.6008 | 0.6602 | 0.4304 | 0.482 | 0.4939 | 0.5711 | 0.5257 | 0.6218 | 0.4463 | 0.6069 | 0.4906 | 0.5863 | 0.4992 | 0.5949 |
| Lipid Particles | 0.0194 | 0.0032 | 0.0033 | 0.0031 | 0.0114 | 0.0041 | 0.0157 | 0.004 | 0.0068 | 0.0064 | 0.0076 | 0.0073 | 0.0336 | 0.0024 | 0.0147 | 0.0042 | 0.0054 | 0.0086 |
| Mitochondria | 0.0122 | 0.0111 | 0.0172 | 0.0138 | 0.0031 | 0.016 | 0.0258 | 0.005 | 0.0194 | 0.0345 | 0.0143 | 0.0124 | 0.017 | 0.0064 | 0.011 | 0.0194 | 0.0073 | 0.0285 |
| None | 0.001 | 0.0001 | 0.0001 | 0.0002 | 0 | 0.0001 | 0.0017 | 0.0004 | 0.0001 | 0.0001 | 0.0001 | 0.0001 | 0.0003 | 0.0027 | 0.0001 | 0 | 0.0001 | 0.0001 |
| Nuclear Periphery | 0.0002 | 0.0001 | 0.0002 | 0.0001 | 0.0001 | 0.0001 | 0.0047 | 0.0003 | 0.0003 | 0.0001 | 0.0002 | 0.0001 | 0.0002 | 0.0001 | 0.0002 | 0.0001 | 0.0002 | 0.0002 |
| Nucleolus | 0.0004 | 0 | 0 | 0 | 0 | 0 | 0.0002 | 0.0001 | 0.0002 | 0 | 0 | 0 | 0 | 0 | 0.0002 | 0 | 0 | 0 |
| Nucleus | 0.0006 | 0.0001 | 0.0001 | 0.0001 | 0 | 0 | 0.001 | 0.0001 | 0.0004 | 0 | 0.0001 | 0 | 0.0001 | 0.0001 | 0.0001 | 0 | 0 | 0 |
| Peroxisomes | 0.0597 | 0.0284 | 0.0202 | 0.0045 | 0.0245 | 0.0122 | 0.0223 | 0.0388 | 0.0268 | 0.0178 | 0.0281 | 0.0219 | 0.0714 | 0.0151 | 0.0265 | 0.0422 | 0.004 | 0.0302 |
| Punctate Nuclear | 0.0009 | 0.0001 | 0.0001 | 0.0001 | 0.0003 | 0.0001 | 0.0027 | 0.0026 | 0.0003 | 0.0001 | 0.0001 | 0.0002 | 0.0005 | 0.0002 | 0.0003 | 0.0001 | 0.0001 | 0.0002 |
| Vacuole | 0.0011 | 0.0015 | 0.0021 | 0.0015 | 0.0005 | 0.0013 | 0.0035 | 0.0025 | 0.0016 | 0.0008 | 0.0016 | 0.0008 | 0.0011 | 0.0012 | 0.0036 | 0.0009 | 0.0025 | 0.0009 |
| Vacuole Periphery | 0.0012 | 0.0015 | 0.002 | 0.0017 | 0.0008 | 0.0021 | 0.0026 | 0.0013 | 0.0018 | 0.0013 | 0.0019 | 0.0012 | 0.0011 | 0.0008 | 0.002 | 0.0015 | 0.0028 | 0.0015 |
Sequencing Data
| R1 | R2 | |||||||||
|---|---|---|---|---|---|---|---|---|---|---|
| G1 Post-START | S/G2 | Metaphase | Anaphase | Telophase | G1 Post-START | S/G2 | Metaphase | Anaphase | Telophase | |
| Gene Expression | 45.9752 | 37.3627 | 34.2779 | 30.347 | 35.4697 | 22.785 | 27.9896 | 30.5967 | 24.5618 | 35.7954 |
| Translational Efficiency | 0.7217 | 0.655 | 0.695 | 0.713 | 0.6823 | 1.1873 | 1.0459 | 0.7485 | 0.8954 | 0.825 |
Hit Data
| Dataset | Hit |
|---|---|
| Protein Concentration | ✘ |
| Protein Localization | ✘ |
| Gene Expression | ✘ |
| Translational Efficiency | ✘ |
Endocytosis
| Temp | Actin Patch (Sac6-tdTomato) | Cortical Patch (Sla1-GFP) | Late Endosome (Snf7-GFP) | Vacuole (Vph1-GFP) |
|---|---|---|---|---|
| 37℃ | ||||
| RT |
Cell Cycle Omics
CYCLoPs (Apm3-GFP)
| Gene / Allele | Actin Patch (Sac6-tdTomato) | Cortical Patch (Sla1-GFP) | Late Endosome (Snf7-GFP) | Vacuole (Sac6-tdTomato) |
|---|
| Gene | Images |
|---|
| Gene | Images |
|---|
Images are not yet available
Images are not yet available